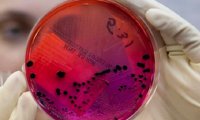
Заражение сибирской язвой связано с использованием винтажных предметов

В Кемерове мужчина срубил топором спутниковую антенну
Полицейские в ходе проведения розыскных мероприятий установили личность и задержали злоумышленника. Им оказался тридцатидвухлетний ранее судимый кемеровчанин.
Полицейские в ходе проведения розыскных мероприятий установили личность и задержали злоумышленника. Им оказался тридцатидвухлетний ранее судимый кемеровчанин.
В комментариях пользователи писали, что под колесами чуть не пострадали дети, а сидящие в машине смеялись от того, что люди разбегаются. «Мазда» совершала опасные маневры
Схватив металлическую урну, стоявшую при выходе на улице, девушка с силой ударила ею по стеклянной двери помещения, разбив ее. После этого с чувством выполненного долга хулиганка отправилась восвояси.
В скором времени оба транспортных средства правоохранители нашли с опустошенными бензобаками. В салоне одной из машин была обнаружена фотография женщины.
Специалисты предупредили о вреде использования средств для бритья вроде помазков и опасной бритвы, которые сегодня снова входят в моду. По мнению специалистов, кисточка-помазок, изготовленная из...
Депутаты Госдумы Анатолий Аксаков, Игорь Дивинский и член Совфеда Николай Журавлев подготовили поправки в закон «О защите прав потребителей», с которыми ознакомился РБК.
По итогам переговоров вице-премьеров России и Белоруссии Аркадия Дворковича и Владимира Семашко стороны подписали пакет документов, урегулировав все существовавшие проблемы.

Глава Минэкономразвития Максим Орешкин представил три сценария социально-экономического развития на 2018-2020 годы. Правительство приняло за основу базовый прогноз МЭР.
Европейский вещательный союз ответил на заявление «Первого канала». Ранее телеканал объявил, что предложенные варианты не принимает и отказывается от трансляции конкурса.
Многие начинают свой день с чашки кофе, так как думают, что нет более бодрящего средства. Эксперты назвали продукты, которые помогут проснуться лучше всякого кофе.
В интервью газете «Известия» глава Минстроя Михаил Мень рассказал о тарифах ЖКХ и о том, как жители могут влиять на цифры в квитанциях и обустройство своих дворов.
Качественная акустика и видеотехника определяет статус хозяина жилья: для многих обладателей такой техники приверженность к определенному бренду или дизайну является привычкой.
Перед тем, как потратить деньги в незнакомом магазине, большинство пользователей проверяют продавца – ищут и читают отзывы других покупателей. Никто не хочет отдать деньги мошенникам, даже если речь...
О достижении договоренностей с испанской компанией Inditex рассказал журналистам заместитель министра промышленности и торговли России Виктор Евтухов.
Традиционные способы обучения будут актуальны всегда. Многим поколениям студентов еще придется посещать лекции, ходить в библиотеку, присутствовать на лекциях и семинарах, и сдавать экзамены...
Президент России Владимир Путин на следующий день после встречи в Москве с госсекретарем США Рексом Тиллерсоном обсудил ситуацию в Сирии с постоянными членами Совета безопасности РФ. Об этом сообщает...
В Кремле оправдали заместителя постоянного представителя России при ООН Владимира Сафронкова, который отличился резкими высказываниями на заседании Совета Безопасности ООН, во время обсуждения...

Пресс-секретарь президента Дмитрий Песков рассказал РБК, что беседа президента Владимира Путина с главой Госдепартамента США Рексом Тиллерсоном прошла «достаточно конструктивно».

Бизнесмен Алишер Усманов обратился в суд с иском к оппозиционеру Алексею Навальному и основанному им Фонду борьбы с коррупцией, говорится в сообщении пресс-службы Люблинского суда Москвы.

Формулировка, согласно которой Россия не предприняла достаточных мер для предотвращения теракта в Беслане, неприемлема, заявил пресс-секретарь президента РФ Дмитрий Песков. Ранее ЕСПЧ обязал Россию...